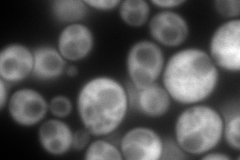
YPL048W
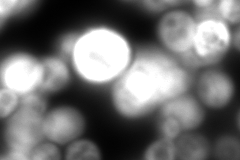
YPL048W
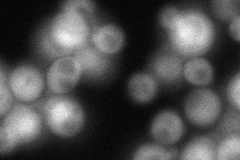
YPL048W
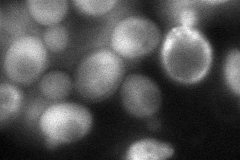
YPL048W
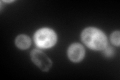
YPL048W

View description
Nuclear protein required for transcription of MXR1; binds the MXR1 promoter in the presence of other nuclear factors; binds calcium and phospholipids; has similarity to translational cofactor EF-1 gamma
Localization:
Intensity:
Fold change:
Significance:
-
C’ GFP library in SD

cytosol158.57 -
N' NOP1pr-GFP in SD
cytosol448.662 -
N' TEF2pr-mCherry in SD
cytosol5.24081 -
N' NATIVEpr-GFP in SD
cytosol96.7188 -
N' TEF2pr-VC and Cyto-VN in SD
cytosol85.5504 -
C’ GFP library in SD+DTT
cytosol177.331.11No -
C’ GFP library in SD+H2O2

cytosol177.331.11No -
C’ GFP library in Starvation Media

cytosol79.990.5Yes -
C’ GFP library on the background of Pup2-DaMP

cytosol -
C’ GFP library on the background of CCT mutant

cytosol167.8671.05852No
